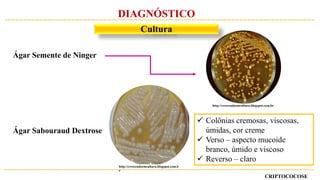
Ágar Semente de Ninger
Ágar Sabouraud Dextrose
 Colônias cremosas, viscosas,
úmidas, cor creme
 Verso – aspecto mucoide
branco, úmido e viscoso
 Reverso – claro
http://crescendoemcultura.blogspot.com.br
http://crescendoemcultura.blogspot.com.b
r
CRIPTOCOCOSE
DIAGNÓSTICO
Cultura

[1] A criptococose é uma micose sistêmica causada pelo fungo Cryptococcus, que pode acometer os pulmões, sistema nervoso central e outros órgãos. [2] Os principais sintomas incluem tosse, dor torácica e cefaleia, dependendo da localização da infecção. [3] O diagnóstico é realizado por meio de exames diretos, cultura, histopatologia e testes sorológicos dos espécimes clínicos, e o tratamento é feito com antifúngicos como anfotericina B